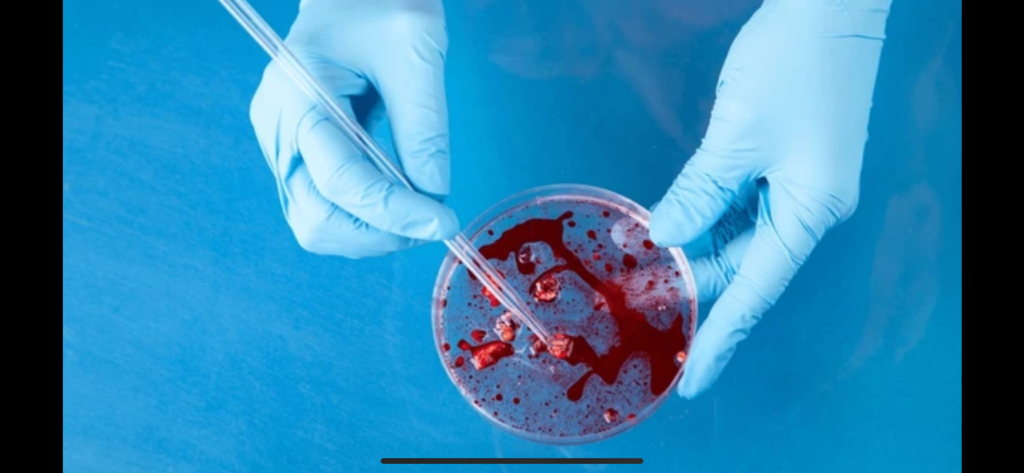

Avanzar en la precisión del diagnóstico y tratamiento del cáncer es cada vez más necesario, pues tan solo en el 2022, se presentaron 20 millones de casos nuevos y 9,7 millones de muertes en el mundo a causa de esta enfermedad. Para alcanzar ese propósito, la participación de bacteriólogos en la implementación de tecnologías avanzadas como la biología molecular y la genética es clave.
De acuerdo con datos del Registro Único Nacional de Talento Humano en Salud, en Colombia hay alrededor de 27 mil bacteriólogos titulados, muchos de ellos, a través de su enfoque multidisciplinario, trabajan en pro de la innovaciónen la atención médica del cáncer, respondiendo a los desafíos y fortaleciendo la calidad de los servicios de salud que reciben los pacientes.
El bacteriólogo, profesional clave en la biología molecular
En el campo de la biología molecular aplicada al cáncer, el bacteriólogo tiene un papel relevante, al realizar pruebas avanzadas como PCR, secuenciación y paneles genéticos para identificar biomarcadores específicos, como genes, proteínas u otras sustancias que permiten conocer detalles relevantes sobre el cáncer. Esto se traduce en diagnósticos tempranos, tratamientos más precisos y personalizados, así como la reducción de la mortalidad asociada a esta patología.
De acuerdo con Diana Montaña, directora de acceso de FICMAC, “la capacitación constante es una habilidad esencial en esta profesión, lo cual permite dominar técnicas e interpretar resultados genómicos. Además, para tomar decisiones clínicas individuales, los bacteriólogos cuentan con habilidades en bioinformática, manejo de bases de datos genéticas, validación de pruebas, control de calidad y capacidad de análisis crítico.